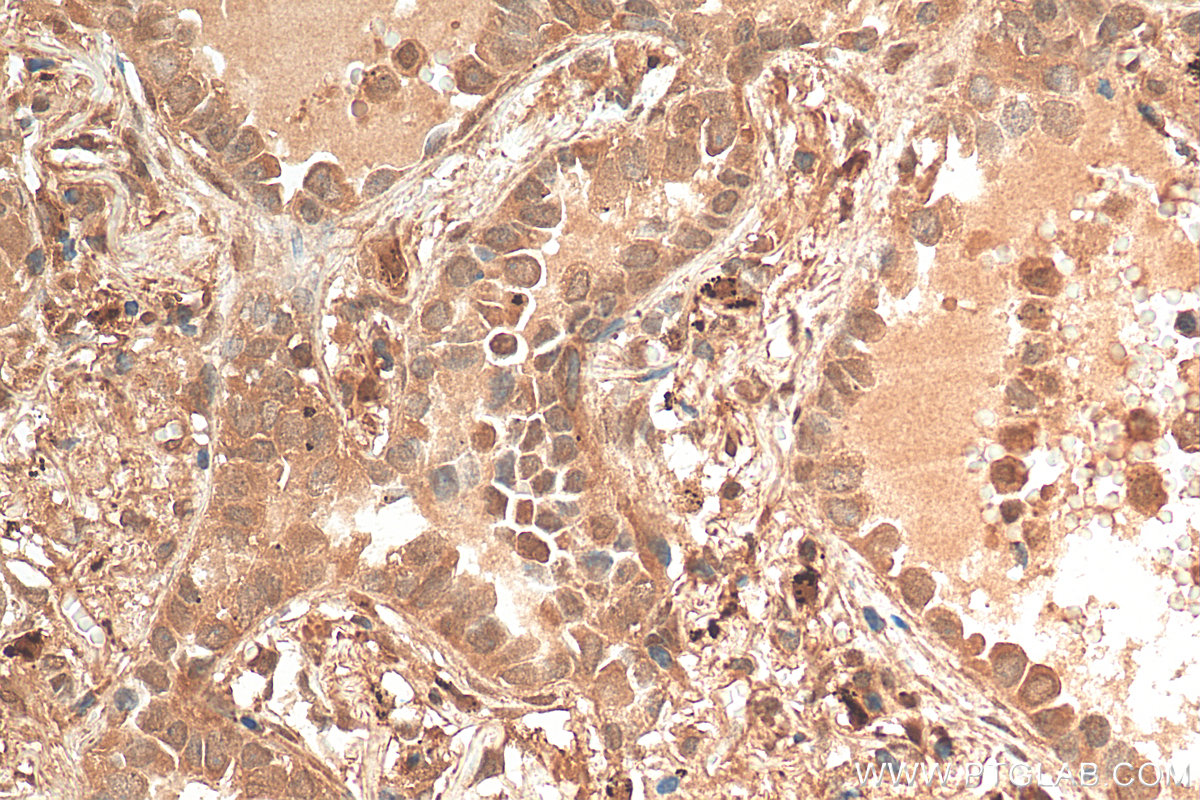

验证数据展示
经过测试的应用
| Positive WB detected in | HeLa cells, Jurkat cells, K-562 cells, MOLT-4 cells |
| Positive IP detected in | HeLa cells |
| Positive IHC detected in | human cervical cancer tissue, human lung cancer tissue, human breast cancer tissue Note: suggested antigen retrieval with TE buffer pH 9.0; (*) Alternatively, antigen retrieval may be performed with citrate buffer pH 6.0 |
| Positive IF/ICC detected in | K-562 cells |
推荐稀释比
| 应用 | 推荐稀释比 |
|---|---|
| Western Blot (WB) | WB : 1:1000-1:6000 |
| Immunoprecipitation (IP) | IP : 0.5-4.0 ug for 1.0-3.0 mg of total protein lysate |
| Immunohistochemistry (IHC) | IHC : 1:50-1:500 |
| Immunofluorescence (IF)/ICC | IF/ICC : 1:50-1:500 |
| It is recommended that this reagent should be titrated in each testing system to obtain optimal results. | |
| Sample-dependent, Check data in validation data gallery. | |
产品信息
12071-1-AP targets STAT5A/B in WB, IHC, IF/ICC, IP, ELISA applications and shows reactivity with human samples.
| 经测试应用 | WB, IHC, IF/ICC, IP, ELISA Application Description |
| 文献引用应用 | WB, IF, IP |
| 经测试反应性 | human |
| 文献引用反应性 | human, mouse, rat |
| 免疫原 |
CatNo: Ag2709 Product name: Recombinant human STAT5B protein Source: e coli.-derived, PGEX-4T Tag: GST Domain: 1-351 aa of BC020868 Sequence: MAVWIQAQQLQGEALHQMQALYGQHFPIEVRHYLSQWIESQAWDSVDLDNPQENIKATQLLEGLVQELQKKAEHQVGEDGFLLKIKLGHYATQLQNTYDRCPMELVRCIRHILYNEQRLVREANNGSSPAGSLADAMSQKHLQINQTFEELRLVTQDTENELKKLQQTQEYFIIQYQESLRIQAQFGPLAQLSPQERLSRETALQQKQVSLEAWLQREAQTLQQYRVELAEKHQKTLQLLRKQQTIILDDELIQWKRRQQLAGNGGPPEGSLDVLQSWCEKLAEIIWQNRQQIRRAEHLCQQLPIPGPVEEMLAEVNATITDIISALVTSTFIIEKQPPQVLKTQTKFAAT 种属同源性预测 |
| 宿主/亚型 | Rabbit / IgG |
| 抗体类别 | Polyclonal |
| 产品类型 | Antibody |
| 全称 | signal transducer and activator of transcription 5B |
| 别名 | STAT5B, STAT5 |
| 计算分子量 | 787 aa, 90 kDa |
| 观测分子量 | 90 kDa |
| GenBank蛋白编号 | BC020868 |
| 基因名称 | STAT5B |
| Gene ID (NCBI) | 6777 |
| ENSEMBL Gene ID | ENSG00000173757 |
| RRID | AB_2196933 |
| 偶联类型 | Unconjugated |
| 形式 | Liquid |
| 纯化方式 | Antigen affinity purification |
| UNIPROT ID | P51692 |
| 储存缓冲液 | PBS with 0.02% sodium azide and 50% glycerol, pH 7.3. |
| 储存条件 | Store at -20°C. Stable for one year after shipment. Aliquoting is unnecessary for -20oC storage. |
背景介绍
STAT5B belongs to the transcription factor STAT family. In response to cytokines and growth factors, STAT family members are phosphorylated by the receptor associated kinases, and then form homo- or heterodimers that translocate to the cell nucleus where they act as transcription activators. STAT5B carries out a dual function: signal transduction and activation of transcription. STAT5B mediates the signal transduction triggered by various cell ligands, such as IL2, IL4, CSF1, and different growth hormones. It has been shown to be involved in diverse biological processes, such as TCR signaling, apoptosis, adult mammary gland development, and sexual dimorphism of liver gene expression. Although this antibody is a rabbit polyclonal antibody raised against residues near the N terminus of human STAT5B, the homology between this segment and the corresponding segment of human STAT5A is 95%. It shows that this antibody can cross-react with STAT5A.
实验方案
| Product Specific Protocols | |
|---|---|
| IF protocol for STAT5A/B antibody 12071-1-AP | Download protocol |
| IHC protocol for STAT5A/B antibody 12071-1-AP | Download protocol |
| IP protocol for STAT5A/B antibody 12071-1-AP | Download protocol |
| WB protocol for STAT5A/B antibody 12071-1-AP | Download protocol |
| Standard Protocols | |
|---|---|
| Click here to view our Standard Protocols |
发表文章
| Species | Application | Title |
|---|---|---|
Biomed Pharmacother Kuijieling regulates the differentiation of Treg and Th17 cells to ameliorate experimental colitis in rats. | ||
Br J Pharmacol HSP90β shapes the fate of Th17 cells with the help of glycolysis-controlled methylation modification | ||
Pharm Biol Yiguanjian decoction inhibits macrophage M1 polarization and attenuates hepatic fibrosis induced by CCl4/2-AAF. | ||
Biochem Biophys Res Commun 1, 25(OH)2D3-induced interaction of vitamin D receptor with p50 subunit of NF-κB suppresses the interaction between KLF5 and p50, contributing to inhibition of LPS-induced macrophage proliferation. | ||
Iran J Basic Med Sci Quercetin of huoxuehuayu tongluo decoction and azithromycin combination therapy effectively improves rat tubal factor infertility by inhibiting inflammation |